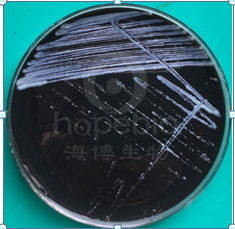
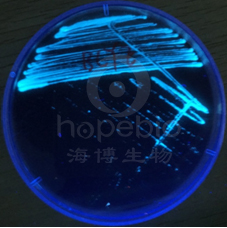

海博微信公众号
海博微信公众号
 海博天猫旗舰店
海博天猫旗舰店


 海博微信公众号
海博微信公众号
 海博天猫旗舰店
海博天猫旗舰店




此培养基常用于军团菌的分离培养,也可制备成BCYE-CYS培养基。
军团菌生长缓慢,一般需在2.5%二氧化碳气体环境下可生长良好,并且对铁盐和半胱氨酸具有依赖性。此培养基中的酵母浸粉和α-酮戊二酸可为军团菌的生长提供基本营养和能源;ACES缓冲剂(N-2-乙酰氨基乙醇磺酸)可使军团菌不需二氧化碳,在空气环境中即能生长;活性炭具有解毒、收集二氧化碳和改变表面张力的作用;L-半胱氨酸盐酸盐和焦磷酸铁为军团菌的必须生长因子。若配制培养基时不添加L-半胱氨酸盐酸盐,可制成BCYE-CYS培养基,用于军团菌的鉴别培养。
二、成分(g/L):
酵母浸粉...................10.0
ACES缓冲剂..............10.0
活性炭.......................2.0
α-酮戊二酸..............1.0
琼脂...........................15.0
L-半胱氨酸盐酸盐....0.4(灭菌后添加)
可溶性焦磷酸铁.......0.25(灭菌后添加)
PH:6.8±0.2
三、实验现象:

博兹曼军团菌在此培养基中生长良好,培养72-120h后形成灰白色菌落(左图),在紫外灯照射下观察可见到蓝绿色荧光(右图);若接种至BCYE-CYS培养基中则不生长。多数非目标菌在BCYE和BCYE-CYS培养基中均可生长,无荧光现象。
相关产品:
注:本文属海博生物原创,未经允许不得转载。
上一篇:UVM培养基的原理及使用方法



